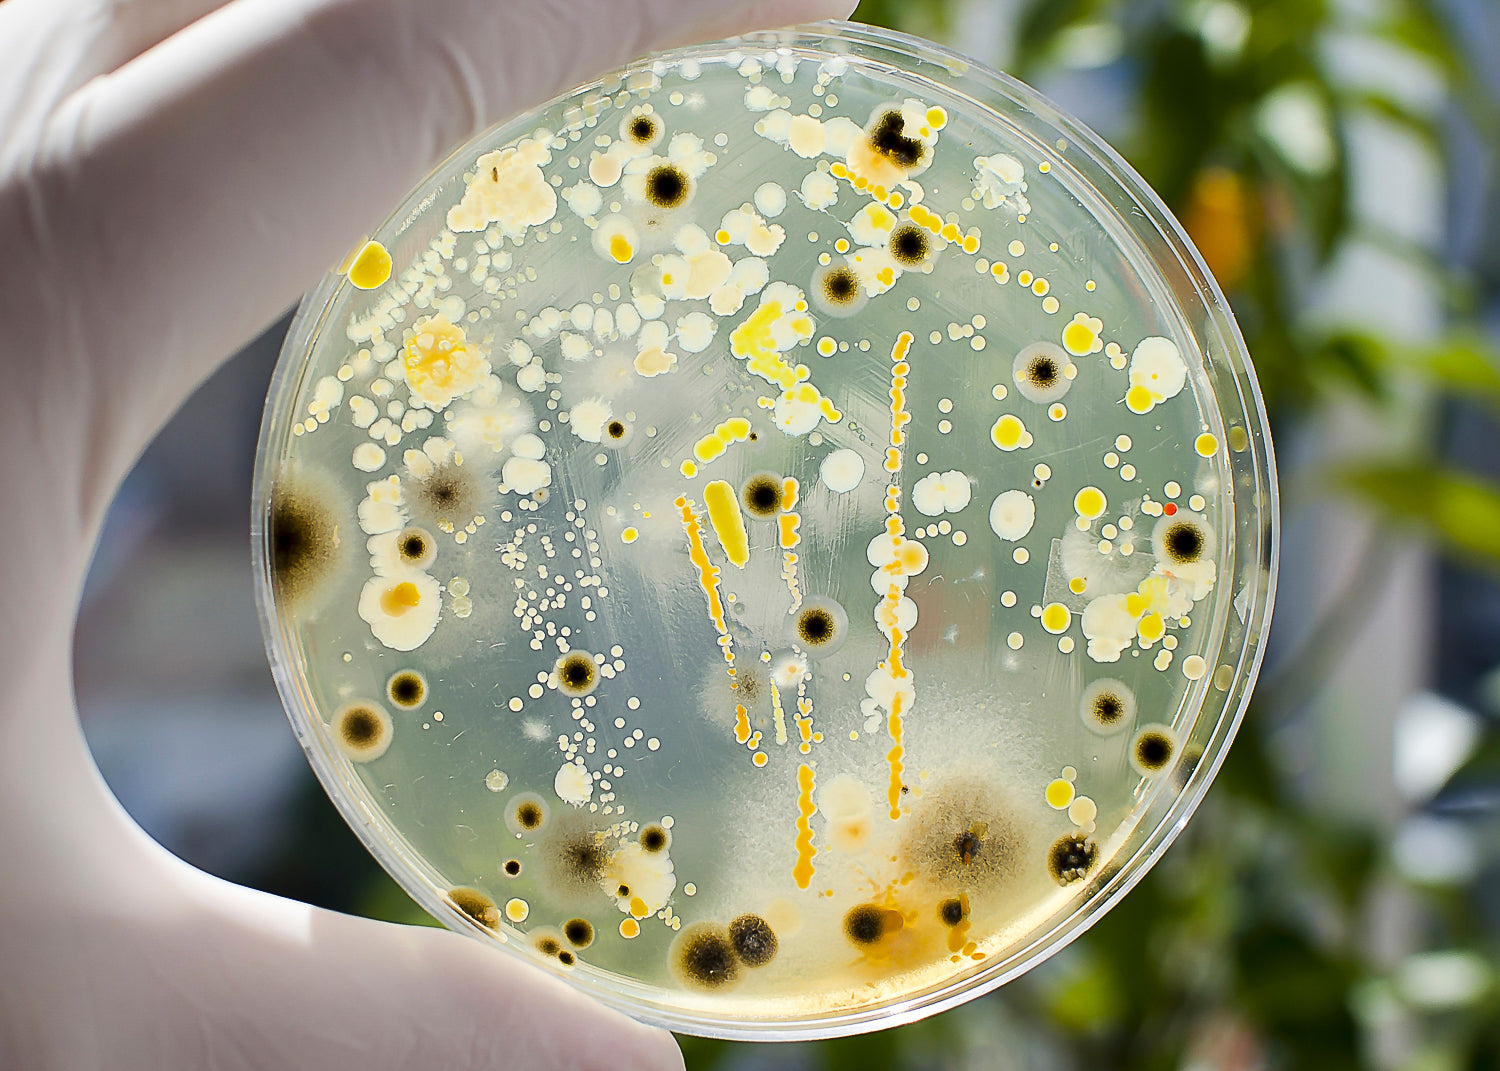

Your Partner for Bespoke Environmental Solutions
Over the past 20 years of being in business, we at SPCB (UK) Limited have seen a lot of changes, often for the better, in the attitude of industry towards making improvements to its environmental impact. Working with European partners, we have always been innovative in our support and services, including the improvement of air filtration and the recycling of waste water.
The recent COP26 climate summit highlighted the need for industry to make improvements in its technologies and move towards a green future.
SPCB (UK) Limited provides bespoke solutions and can help you with your goals and aspirations. For example, much of our range has moved from traditional solvents to more ecological water-based solutions. Our laboratory is always at the forefront of new technology, working to ensure consistency in quality and is equipped in the latest equipment such as salt spray testing machines for paint adhesion. When you ask us for advice and assistance in developing your own bespoke solutions, you can be assured that we will be working towards the very latest innovations.
Another key area in which we excel is in the installation of equipment for treating, fitering and recycling waste water. These waters can come from paint spray booths, degreasing plants, cleaning rinses (eg spray guns and clerical waste) or general sludge. Each enquiry usually starts with a test of your dirty water free of charge so that we can ascertain the best possible solution for you. We will then work on an installation to suit your needs, space and budget. Not only does this improve your working environment, it will make economical savings.
Working with us as your partner for bespoke environmental solutions, you can and will achieve green status, recycling your waste for ZERO REJECT.

